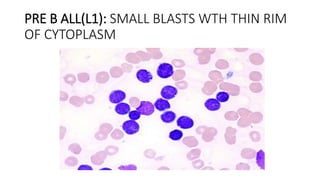
PRE B ALL(L1): SMALL BLASTS WTH THIN RIM
OF CYTOPLASM
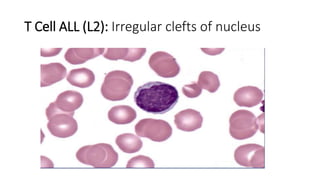
T Cell ALL (L2): Irregular clefts of nucleus

This document discusses acute lymphoblastic leukemia (ALL). It defines ALL as a malignant disorder of hematopoietic stem cells characterized by an increased number of white blood cells in the bone marrow or peripheral blood. ALL is classified based on the type of cell affected (lymphoblastic or myeloid) and whether the disease is acute or chronic. The document describes the epidemiology, risk factors, clinical presentation, investigations including blood tests and bone marrow biopsy, classification systems, treatment involving induction, consolidation and maintenance phases, supportive care, medications used, and prognosis for ALL patients.












![Investigations
• Full blood count- Anemia, thrombocytopenia, leucopenia or leukocytosis.
• Peripheral smear study- Total leucocyte count raised , normal or low,
Normocytic normochromic anemia, Thrombocytopenia
• Coagulation studies (prothrombin time [PT], activated partial
thromboplastin time [aPTT], fibrinogen)
• Renal profile and liver function test- due to tumour lysis syndrome, need to
monitor hyperkalemia, hyperuricaemia, hyperphosphotemia and
hypocalcemia
• Bone marrow aspiration and biopsy- hypercellular replacement of normal
cells by blast cells which more than 20%.
• Blood cultures- obtained in patients with fever and other signs of infection.](https://image.slidesharecdn.com/acutelymphoblasticleukemia-200611201354/85/Acute-lymphoblastic-leukemia-13-320.jpg)